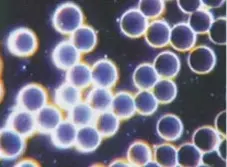
Butiran Darah Setelah Minum NSTM

8IO NSTM
Suplemen mineral terlengkap, 8IO NSTM Prima Jaya mengandung 76 unsur mineral makro & mikro yang bersifat Alami, Murni, Seimbang & Ionik
Tahukah Anda?
Apa Manfaat 8IO NSTM?

BUKTI NYATA MANFAAT 8IO NSTM
Perubahan dramatis tampak pada sampel sel darah yang dilihat melalui mikroskop Nikon dengan pembesaran 15.000 kali

Butiran-butiran darah tanpa minum 8IO NSTM
Butiran-butiran darah setelah minum 8IO NSTM
“RAHASIA HIDUP SEHAT ALAMI”
8IO NSTM
Membantu Mengurangi Lemak Darah
Keunggulan 8IO NSTM Prima Jaya
8IO NSTM Prima Jaya menjadi solusi yang efektif untuk membantu mengatasi proses penanganan berbagai keluhan kesehatan degeneratif yang diderita oleh manusia, antara lain: Alergi, Ambeien, Anemia, Asam Urat, Diabetes, Empedu, Epilepsi, Gangguan Otak, Gondok, Ginjal, Hati, Hipertensi, Impotensi, Insomnia, Jantung, Kanker, Katarak, Kecerdasan, Kesuburan, Kolesterol, Leukemia, Maag, Pencernaan, Paru-paru, Osteoporosis, Reumatik, Sendi & Tulang, Stress, Stroke, dll.
Bingung Pilih Suplemen Mineral?
Manfaat dan Khasiat Mineral 8IO NSTM Lainnya

Cara Pemakaian 8IO NSTM
Dewasa Sehat :
Anak-anak :
Apa Kata Mereka Tentang 8IO NSTM


8IO NSTM TERJAMIN & AMAN Dikonsumsi
Tidak perlu khawatir, 8IO NSTM Prima Jaya sudah mengantongi ijin dari BPOM untuk keamanan dan kenyamanan anda.


Miliki Kehidupan Sehat Alami Bersama
8IO NSTM

Rp 300.000
Mau ORDER atau Konsultasi Produk Prima Jaya dengan admin kami?
Boleh banget, Klik tombol di bawah ini untuk chat admin.
Konsultasi dan Pemesanan:
Disclaimer :
Hasil yang didapatkan bisa berbeda untuk setiap orang, kami tidak menjamin bahwa Anda juga akan mendapatkan manfaat yang sama seperti mereka, karena kondisi tubuh setiap orang berbeda-beda.
